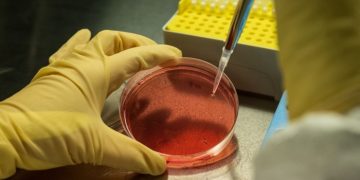
Fund for struggling biotechs takes aim at ‘tragedy’ for shareholders
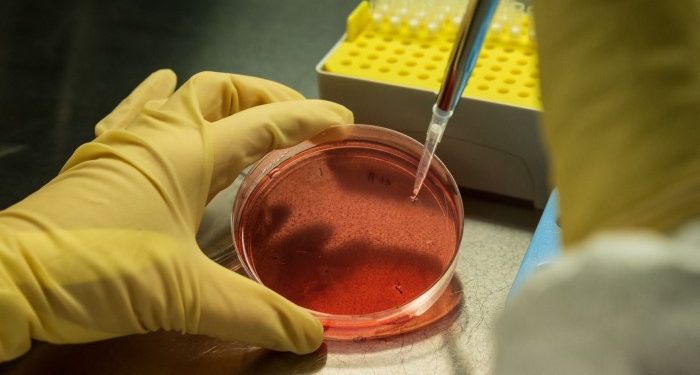
Fund for struggling biotechs takes aim at ‘tragedy’ for shareholders

Unlock the Editor’s Digest totally free
Roula Khalaf, Editor of the FT, selects her favorite tales on this weekly e-newsletter.
A veteran banker and former pharma R&D chief are launching a fund that can purchase up among the almost 300 listed biotechs which have had disappointing medical trials, returning money to shareholders and buying any invaluable mental property.
Alis Biosciences then plans to checklist, hoping to draw massive traders akin to Constancy and Wellington by providing them a straightforward method to unfold their bets throughout the business. It estimates that listed biotechs have a complete of about $30bn in money on their stability sheets.
Nick Johnston, a former biotech banker and entrepreneur, mentioned the fallout from a chronic market rout within the sector for the reason that pandemic has been a “tragedy” for shareholders.
He calculates that struggling listed biotechs have market capitalisations starting from $5mn to $100mn however with money reserves from $10mn to $400mn every.
“The basic downside is that there’s simply an excessive amount of money within the fallacious place in the intervening time,” he mentioned.
Annalisa Jenkins, former head of R&D at German drugmaker Merck, will chair the board. After it lists, Alis Biosciences plans to attempt to develop among the early stage medicine candidates, together with by bringing collectively separate concepts from its varied acquisitions.
The S&P XBI index, which tracks the efficiency of biotech shares, remains to be 50 per cent down from its excessive in February 2021.
Through the pandemic, traders grew to become enthusiastic in regards to the sector, permitting a lot of start-ups to go public, usually at a a lot earlier stage within the dangerous means of drug discovery and growth than regular.
Johnston mentioned that when early medical trials gave poor outcomes, the shares usually tumbled to this point that traders have been caught with them as a result of that they had no patrons.
Administration groups have regularly been joyful to hold on and check out completely different approaches as a result of they nonetheless have money raised within the growth occasions, he added. A number of the new concepts have been like “lemmings off a cliff”, he mentioned, as a result of they have been based mostly on science that had not labored in trials.
Alis Biosciences will worth the businesses at 90 per cent of the market capitalisation, borrowing cash to purchase them after which returning a lot of the stability sheet money to traders.
Johnston mentioned Alis would have the ability to return cash far quicker than the if there have been a chapter course of.
“We solely ask two questions: do you personal the mental property and have you ever dedicated any fraud? Proper, that’s all we have to know,” he mentioned.
Jenkins mentioned traders have expressed “robust assist” for Alis Biosciences “reflecting demand for a brand new answer to this long-standing downside”.
“On this difficult monetary market setting, there’s a want for higher creativity to seek out solutions,” she mentioned.